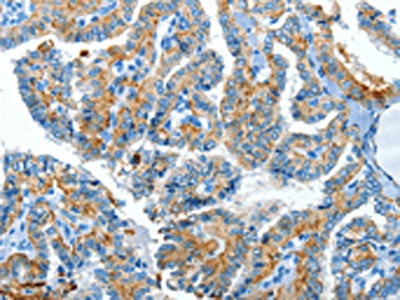

CLPTM1L Antibody
-
中文名稱:CLPTM1L兔多克隆抗體
-
貨號(hào):CSB-PA017010
-
規(guī)格:¥1100
-
圖片:
-
The image on the left is immunohistochemistry of paraffin-embedded Human thyroid cancer tissue using CSB-PA017010(CLPTM1L Antibody) at dilution 1/60, on the right is treated with synthetic peptide. (Original magnification: ×200)
-
The image on the left is immunohistochemistry of paraffin-embedded Human esophagus cancer tissue using CSB-PA017010(CLPTM1L Antibody) at dilution 1/60, on the right is treated with synthetic peptide. (Original magnification: ×200)
-
-
其他:
產(chǎn)品詳情
-
Uniprot No.:
-
基因名:
-
別名:CLPTM1L; CRR9; Cleft lip and palate transmembrane protein 1-like protein; CLPTM1-like protein; Cisplatin resistance-related protein 9; CRR9p
-
宿主:Rabbit
-
反應(yīng)種屬:Human
-
免疫原:Synthetic peptide of Human CLPTM1L
-
免疫原種屬:Homo sapiens (Human)
-
標(biāo)記方式:Non-conjugated
-
抗體亞型:IgG
-
純化方式:Antigen affinity purification
-
濃度:It differs from different batches. Please contact us to confirm it.
-
保存緩沖液:-20°C, pH7.4 PBS, 0.05% NaN3, 40% Glycerol
-
產(chǎn)品提供形式:Liquid
-
應(yīng)用范圍:ELISA,IHC
-
推薦稀釋比:
Application Recommended Dilution ELISA 1:1000-1:5000 IHC 1:50-1:200 -
Protocols:
-
儲(chǔ)存條件:Upon receipt, store at -20°C or -80°C. Avoid repeated freeze.
-
貨期:Basically, we can dispatch the products out in 1-3 working days after receiving your orders. Delivery time maybe differs from different purchasing way or location, please kindly consult your local distributors for specific delivery time.
-
用途:For Research Use Only. Not for use in diagnostic or therapeutic procedures.
相關(guān)產(chǎn)品
靶點(diǎn)詳情
-
功能:Enhances cisplatin-mediated apoptosis, when overexpressed.
-
基因功能參考文獻(xiàn):
- using multivariate logistic regression, we observed that haplotype CLPTM1L is significantly associated with poor treatment response PMID: 29450669
- research seems to provide strong evidence for an association between CLPTM1L rs402710C/T and TERT rs2736100A/C SNPs and the risk of OSSC, and suggests that higher tumor RTL values and positive hTERT expression may be applicable as early prognostic markers PMID: 28025427
- Homozygous carriers of the CLPTM1L minor C allele presented with faster 6 years telomeres shortening rate compared to carriers of the major allele. PMID: 27532233
- Variant in CLPTM1L gene is associated with lung cancer susceptibility. PMID: 28335076
- CLPTM1L and TERT have been implicated in cancers, and CIITA is considered as the "master control factor" for the expression of NPC-associated MHC class II genes. These suggested that both SNPs might be functional. Altogether, our findings expand our understanding of the genetic contribution to nasopharyngeal carcinoma (NPC), risk and provide novel biological insights into NPC pathogenesis. PMID: 27436580
- A case-control study examined the potential association of 4 CLPTM1L SNPs (rs4975616, rs402710, rs401681, and rs31489) with lung cancer in a Chinese Han population. Minor alleles of all four were significantly associated with decreased lung cancer risk. PMID: 26852039
- The data demonstrate that CLPTM1L overexpression can predict poor prognosis in patients with lung cancer and suggest that CLPTM1L might be associated with the regulation of cell migration and invasion. PMID: 27062701
- Data suggest that single nucleotide polymorphisms (SNPs) in the telomerase (TERT)-cleft lip and palate transmembrane protein 1-like protein (CLPTM1L) locus may play a role in mediating the susceptibility to nasopharyngeal carcinoma (NPC) in Chinese. PMID: 26621837
- CLPTM1L Polymorphism is associated with Nasopharyngeal Carcinoma. PMID: 26545403
- This meta-analysis suggests that T allele of CLPTM1L-telomerase reverse transcriptase rs401681 polymorphism is associated with an increased PC risk, especially among Chinese. PMID: 25284078
- rs2736100 on TERT-CLPTM1L indicates a poor prognosis for lung cancer in the Chinese Han population. PMID: 25966219
- Whole exome sequencing followed by immunohistochemistry of fibrolamellar hepatocellular carcinoma cell lines and tumors showed two structural variants resulting in fusion transcripts: DNAJB1-PRKCA and CLPTM1L-GLIS3. PMID: 25122662
- miR-494 regulates cell growth, invasion and apoptosis of esophageal squamous cell carcinoma cells by targeting CLPTM1L. PMID: 25480402
- This study showed that genetic variation rs31489 in 5p15.33 was directly associated with the reduced risk of lung cancer in Han Chinese. The CLPTM1L gene rs31489-A allele was a protective factor for the development of lung cancer only in nonsmokers. PMID: 25422207
- CLPTM1L-rs401681 polymorphism was not associated with lung cancer risk in Chinese males. PMID: 24861918
- Six independent risk neoplasm loci marked by common single-nucleotide polymorphisms have been found: five in the TERT gene, and one in CLPTM1L gene, both on chromosome 5. PMID: 25027329
- Polymorphisms of CLPTM1L gene is associated with the risk of hepatocellular carcinoma. PMID: 25339005
- association of the CLPTM1L polymorphism and the risk of the lung cancer in non-smoking females in China PMID: 25037574
- Using TCGA RNASeq data, we found significantly increased expression of both TERT and CLPTM1L in endometrial cancer tissue compared with normal tissue (TERT P = 1.5 x 10(-18), CLPTM1L P = 1.5 x 10(-19)). PMID: 25487306
- TERT-CLPTM1L rs401681 CT and CT/TT genotypes are associated with decreased risk of esophageal squamous cell carcinoma. PMID: 25007268
- CLPTM1L polymorphisms did not affect the tumor sensitivity to cisplatin combination chemotherapy in our study patients. PMID: 25155038
- consumption of alcohol may interact with CLPTM1L polymorphisms to contribute to overall lung cancer susceptibility. PMID: 25526467
- Our meta-analysis provides supportive evidence that CRR9p polymorphism may influence a risk of lung cancer and non-small cell lung cancer in a protective model. PMID: 24957041
- CLPTM1L SNPs (rs401681 and rs4975616) were not associated with non-small cell lung cancer in a non-smoking Han Chinese population. PMID: 24175795
- CLPTM1L polymorphisms rs402710 and rs401681 are risk-conferring factors for the development of lung cancer. [Meta-analysis] PMID: 24907075
- our study indicated that the CLPTM1L - rs401681 (G>A) polymorphism was significantly associated with decreased lung cancer risk, especially among European populations. PMID: 24634236
- CLPTM1L SNPs are associated with nasopharyngeal carcinoma risk. PMID: 24615621
- the role of TERT-CLPTM1L variants in the etiology of esophageal squamous cell carcinoma and lung cancer PMID: 24386361
- CLPTM1L rs31489 was a potential biomarker for lung cancer risk in Caucasians PMID: 24535780
- the T allele of rs401681 in CLPTM1L-TERT locus predisposes its carriers to pancreatic cancer. PMID: 24577890
- Results suggest that CLPTM1L functions as a growth-promoting gene in the pancreas and that overexpression may lead to an abrogation of normal cytokinesis. PMID: 24648346
- A protumorigenic role for CLPTM1L that is critical for Ras-driven lung cancers, with potential implications for therapy and chemosensitization. PMID: 24366883
- Genetic variants in TERT and CLPTM1L may affect the susceptibility of lung cancer PMID: 23738012
- results suggest that genetic variants in the TERT-CLPTM1L gene may predispose individuals to be susceptible to lung cancer, particularly non-small cell lung cancer, in the Chinese population PMID: 23359026
- Polymorphism in CLPTM1L gene is associated with lung cancer. PMID: 23908149
- The 5p15.33 locus involving CLPTM1L polymorphisms is significantly associated with lung cancer risk. PMID: 23653681
- Our results reiterate that genetic variants of TERT and CLPTM1L contribute to lung cancer susceptibility in Chinese population. PMID: 23433592
- TERT-CLPTM1L genomic region was associated with increased risk of cancer. PMID: 23707794
- Longer telomere length in peripheral white blood cells is associated with risk of lung cancer and the rs2736100 (CLPTM1L-TERT) polymorphism. PMID: 23555636
- The 5p15.33 region containing telomerase reverse transcriptase gene (TERT) and cleft lip and palate transmembrane protein 1-like (CLPTM1L) gene showed significant association with lung cancer in Han Chinese. PMID: 23368278
- CLPTM1L is a mitochondria protein that may be associated with an anti-apoptotic mechanism which affects drug-resistance in lung cancer cells. PMID: 23300716
- TERT-CLPTM1L rs401681[C] allele is risk factor for basal cell carcinoma but not for squamous cell carcinoma. PMID: 22893025
- association between genetic polymorphism and cancer risk PMID: 23226346
- Further molecular characterization by flow-FISH and quantitative RT-PCR suggest TERT and CLPTM1L as target genes of 5p15.33 rearrangements. PMID: 23137523
- The CT genotype at rs401681 was more common and the TT genotype was rare in patients, and the differences were significant between lung adenocarcinoma patients and controls. This was also true for rs402710. Moreover, the frequency of the GGCTCT haplotype was higher and the TTTTTT frequency was lower in patients, especially those with lung adenocarcinoma. PMID: 22370939
- haplotype G-T-A in CLPTM1L also confers a risk to glioma suggesting CLPTM1L is also involved in the etiology of glioma. PMID: 22213090
- This study implicates anti-apoptotic CLPTM1L function as a potential mechanism of susceptibility to lung tumorigenesis and resistance to chemotherapy. PMID: 22675468
- We genotyped eleven SNPs in 2,892 women of African descent but were unable to detect any significant association between TERT-CLPTM1L SNPs and their predispositions for breast cancer risk. PMID: 22134622
- the TERT-CLPTM1L locus influences melanoma risk. PMID: 21993562
- the lung cancer susceptibility locus Tert-Clptm1l on chromosome 5p15.33 increases the risk for bronchial obstruction and emphysema. PMID: 21622582
顯示更多
收起更多
-
亞細(xì)胞定位:Membrane; Multi-pass membrane protein.
-
蛋白家族:CLPTM1 family
-
數(shù)據(jù)庫鏈接:
Most popular with customers
-
-
YWHAB Recombinant Monoclonal Antibody
Applications: ELISA, WB, IHC, IF, FC
Species Reactivity: Human, Mouse, Rat
-
Phospho-YAP1 (S127) Recombinant Monoclonal Antibody
Applications: ELISA, WB, IHC
Species Reactivity: Human
-
-
-
-
-